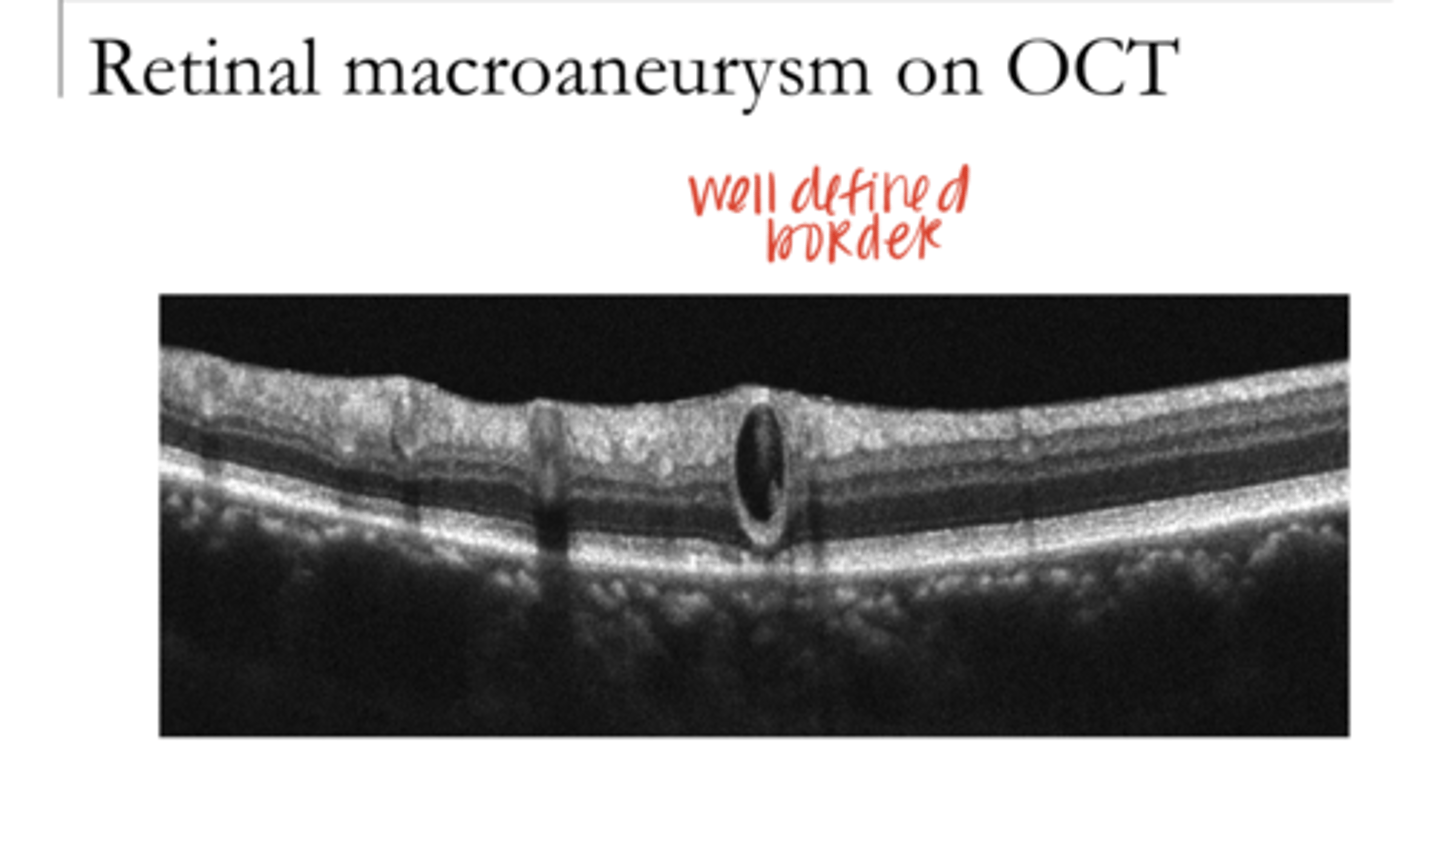
<p>Retinal Macroaneurysm on OCT (Pic)</p>

1/88
Looks like no tags are added yet.
Name | Mastery | Learn | Test | Matching | Spaced | Call with Kai |
|---|
No analytics yet
Send a link to your students to track their progress
blood vessels that develop within existing vessels, usually near areas of nonperfusion
What is retinal collaterization?
venous occlusion
What is the #1 reason for retinal collaterization?
-capillary to capillary
-vein to vein
-artery to artery
-artery to vein
Location of retinal collaterization
shunt
If connections are between vessels of different types they are called _____ vessels
No -- these are connections between 2 vessels that have a plan
Is retinal collaterization the same as neovascuarization?
1) Collaterals connect preexisting vessels with a plan. Neo grows to nowhere with no plan (no organization).
2) Collaterals do not leak with fluorescein angiography. Neovasc vessels always leak.
What are the 2 reasons in which retinal collaterals are different than venous occlusions?
Yes -- can reroute blood if there is a blockage to reestablish circulation. Helpful when you need an alternative route.
Are retinal collaterals effective in establishing new pathways of blood flow in the retina?

retinal venous occlusion
What is the #1 cause of retinal collaterization?
Retinal Collaterals -- Vascular Sheathing, Hard Exudate, and Retinal Collaterals (Pic)
Retinal Collaterals -- Vascular Sheathing, Hard Exudate, and Retinal Collaterals (Pic)

Retinal Collaterals (Pic)
Retinal Collaterals (Pic)

Yes -- patients may not know they had these events.
Area can be damaged w/ VF loss.
Is it hard to recognize a venous occlusion after the fact once all the blood & edema clear?

true
True or False:
Patient needs a vascular workup after a venous occlusive event

1) Congenital
2) Glaucoma
3) Optic nerve tumor (progressive VF defect or central visual loss, optic atrophy, and optic nerve head edema)
4) Post CRVO
EXAM QUESTION:
What are the potential causes for optic nerve head shunt vessels (connecting choroidal circulation into the retinal circulation)?
Optic nerve head shunt vessels -- Opto-ciliary shunt vessels (Pic)
Optic nerve head shunt vessels -- Opto-ciliary shunt vessels (Pic)

Rule out all other causes for a ONH shunt vessel (glaucoma, mental defects, VF defect, ONH edema, CRVO)
If a 15 year old comes into office with a optic nerve head shunt vessels, what should you do?
OCT-A images of retinal collaterals (Pic)
OCT-A images of retinal collaterals (Pic)

No
Do normal retinal vessels cross the midline?

Yes
Can retinal collaterals or neovasc cross the midline?

Intraretinal Microvascular Abnormalities (IRMA) (Pic)
Intraretinal Microvascular Abnormalities (IRMA) (Pic)

IRMA will loop out from the same vessel and then connect to the same vessel again. Retinal collaterals go from one vessel to another.
What is the main difference between IRMA and retinal collaterals after venous occlusion?

No -- unlike neovasc
Does IRMA leak?

diabetic retinopathy
When is IRMA common?

veins
Retinal vessel tortuosity is esp common in the retinal (arteries/veins)
retinal hypoxia -- indicating poor perfusion
What is retinal vessel tortuosity an important sign of?
Retinal Vessel Tortuosity (Pic)
Retinal Vessel Tortuosity (Pic)

deposition/thickening of the retinal blood vessel walls
What is vascular sheathing?

lipid, collagen, fibrin, hyaline, calcium
What material is deposited in retinal vascular sheathing?

-arterosclerosis (age-related or hypertension)
-vascular occlusion (mostly venous)
-inflammation of the BV walls (vasculitis or periphlebitis)
EXAM QUESTION:
What does vascular sheathing result from?

Yes
Does hypertension speed up vascular sheathing?
Vascular sheathing (Pic)
Vascular sheathing (Pic)

Arteriosclerosis with Widening of Arterial Light Reflex - Copper Wiring (Pic)
Arteriosclerosis with Widening of Arterial Light Reflex - Copper Wiring (Pic)

Dilated area of major retinal vascular branch
What is a retinal macroaneurysm?

50-80
When do retinal macroaneurysms occur?

systemic hypertension
50% of individuals with retinal macroaneurysms have what?

arteriosclerosis, retinal emboli, could be congenital
Retinal Macroaneurysms can also be associated with what?

edema, exudation, hemorrhage
What can occur d/t retinal macroaneurysms?

Macroanuerysm and Hard Exudate (Pic)
Macroanuerysm and Hard Exudate (Pic)

hyperfluorescence w/ edema and exudate
What will be seen in a patient with a retinal macroaneurysm on OCT?

Macroaneurysm (Pic)
Macroaneurysm (Pic)

Imaging of a Macroaneurysm (Pic)
Imaging of a Macroaneurysm (Pic)

Retinal Macroaneurysm on OCT (Pic)
Retinal Macroaneurysm on OCT (Pic)
every 6 months
If there is a retinal macroaneurysm present with no exudation or hemorrhage, how often should you see the patient?
follow every 1-3 months
If there is a retinal macroaneurysm present with localized hemorrhage or exudates, how often should you see the patient?
Refer
If there is a retinal macroaneurysm present with threat to the macula or risk of edema, what should be done?
inform the PCP regarding the potential for hypertension -- or to assess BP control in patients already diagnosed with hypertension
You should always inform the PCP about what if you spot a retinal macroaneurysm?
material (chunks) within blood vessels
What are retinal emboli?
-carotid
-cardiac
-injected drugs
EXAM QUESTION:
What are retinal emboli most commonly from?
systemic cardiovascular disease
There is a strong association between retinal emboli and what?
may or may not
Will a retinal emboli cause a vascular occlusion?
ocular emergency
A retinal emboli is a what?
-cholesterol
-calcium
-platelets
-Talc
Retinal emboli can consist of what?
Hollenhorst plaque
What is a cholesterol retinal emboli?
shiny yellow to orange, very reflective
What is the appearance of a Hollenhorst plaque?
gray-white & long standing
What is the appearance of a calcium emboli in the retina?
dull white, long plugs
What is the appearance of a platelet plaque in the retina?
shiny, red-yellow
What is the appearance of a Talc retinopathy?
IV drug users
Talc retinopathy usually appears in what patients?
Retinal Embolus (Pic)
Retinal Embolus (Pic)

Retinal Embolus (Pic)
Retinal Embolus -- Hollenhorst Plaque (Pic)

Multiple Emboli with a BRAO (Pic)
Multiple Emboli with a BRAO (Pic)

yes
Is this pic an ocular emergency?

Talc Retinopathy (Pic)
Talc Retinopathy (Pic)

Retinal Emboli on OCT (Pic)
Retinal Emboli on OCT (Pic)

hyperreflective
Retinal Emboli are (hyper/hypo) reflective on OCT

Retinal Artery Occlusion (Pic)
Retinal Artery Occlusion (Pic)

Hyperreflective -- d/t the leakage of material out of the nerve fibers d/t the hypoxic stress
Retinal Artery Occlusion may result in inner retinal thickening on OCT secondary to ischemia. What will be the appearance of this?

Embolus has caused an artery occlusion -- OCULAR EMERGENCY
What is the primary concern ocularly of a retinal emboli?
25% risk of stroke within 4 weeks
Why is a retinal emboli that is causing an artery occlusion an ocular emergency?
hypertension, hyperlipidedema, and maybe diabetes leading to coronary artery disease & carotid artery disease
What are the primary systemic concerns of a retinal emboli?
send the patient for investigation of carotid and cardiac systems within 3-4 days
If there is no retinal artery occlusion AND THE PATIENT IS ASYMPTOMATIC (no stroke like symptoms), what should you do?
this is an emergency!
If there is no retinal artery occlusion BUT THE PATIENT HAS STROKE LIKE SYMPTOMS, what should you do?
-within the choroid and choriocapillaris (sub-RPE)
-between the RPE and sensory retina (sub-retinal)
What is the location of a sub-RPE and subretinal hemes?
-secondary to choroidal neovasc (ingrowth of new vessels from the choroid)
-An extension of deep retinal hemorrhage
Why do most sub-RPE or subretinal hemes occur?
-sub-RPE is gray-green/dark
-Sub-retinal is dark red
What is the color of both a sub-RPE and a subretinal heme?
yellowish exudation
Sub-RPE and subretinal heme may have what?
scar tissue and pigment mottling
Exudate from sub-RPE or subretinal heme is eventually replaced by what?
AMD
What is the #1 cause of sub-RPE and subretinal heme?
Sub-RPE/Subretinal Heme (Pic)
Sub-RPE/Subretinal Heme (Pic)

Sub-RPE/Subretinal Heme (Pic)
Sub-RPE/Subretinal Heme (Pic)

Sub-RPE and subretinal hemorrhage on OCT (Pic)
Sub-RPE and subretinal hemorrhage on OCT (Pic)

Red
What color would this heme be on fundus photo?

Green
What color would this heme be on fundus photo?

aneurysms of the capillaries involving retinal areas
What are idiopathic juxtafoveal retinal telangectasia?
No
Is idiopathic juxtafoveal retinal telangectasia associated with a systemic disease?
Yes
Can idiopathic juxtafoveal retinal telangectasia leak into the macula?
Macular Telangectasia (Pic)
**group togethered retinal aneurysms
Macular Telangectasia (Pic)
**group togethered retinal aneurysms

retinal vasculopathy (nonspecific vascular problems)
What is a potential cause of ERM?
ERM (Pic)
ERM (Pic)

ERM on OCT (Pic)
ERM on OCT (Pic)